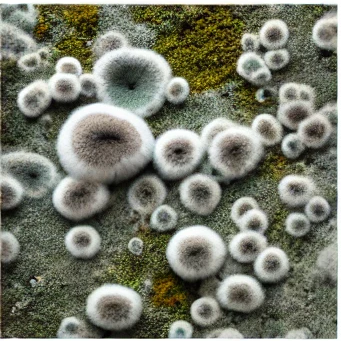
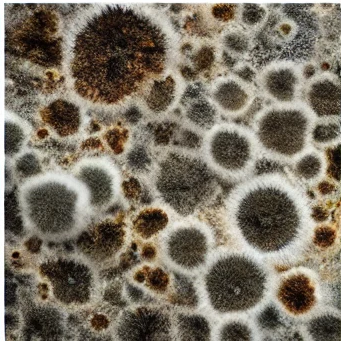
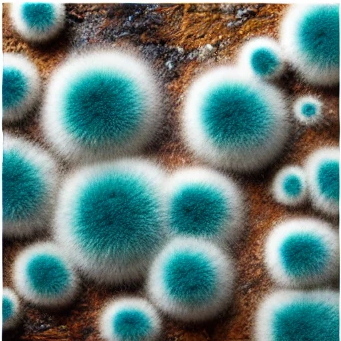

티스토리 뷰
목차
여름철 제습제를 사용하지 않으면 옷장에 곰팡이균이 생깁니다. 여름철에는 장마도 있고 비가 많이 와서 대기가 습합니다. 그러다 보면 옷에서 수분을 가지고 있어요. 그러면 꽉 막힌 옷장 안이 곰팡이가 자라는 환경이 만들어집니다.
옷장 안의 곰팡이는 일반적으로 검은곰팡이라고 부릅니다. 가장 독성이 강한 곰팡이 중 하나이며 심각한 건강 위험을 초래할 수 있습니다.
곰팡이를 방치하면 피부 발진, 가려움증, 재채기, 코막힘 등 호흡기 질환이 발생할 수 있습니다.
가장 좋은 건 곰팡이가 생기지 않도록 제습제를 미리 사용하는 게 가장 좋습니다.
✅아래 제습제 추천 Best3 버튼을 통해 바로 확인 하시기 바랍니다.
"이 포스팅은 쿠팡 파트너스 활동의 일환으로, 이에 따른 일정액의 수수료를 제공받습니다"
여름철이 다가오면 많은 사람들은 불쾌지수가 급격히 올라가는 것을 느낄 수 있습니다. 더운 날씨와 함께 습도까지 높아지면 실내 환경은 더욱 불쾌해집니다. 이런 시기에 제습기는 필수 아이템으로 떠오르는데요, 이번 글에서는 여름철에 제습제가 왜 필요한지, 그 중요성에 대해 알아보겠습니다.
옷장 제습제 습기 제거로 인한 건강 보호
여름철 습한 환경은 우리 건강에 부정적인 영향을 미칠 수 있습니다. 습기가 많은 곳에서는 곰팡이와 집먼지 진드기가 쉽게 번식할 수 있는데, 이는 알레르기나 천식 같은 호흡기 질환을 유발할 수 있습니다. 또한, 습도가 높아지면 피부 질환도 악화될 수 있습니다. 옷장제습제 추천 제품을 사용하면 이러한 유해한 습기를 줄여주어 건강을 지킬 수 있습니다. 한 연구에 따르면, 실내 습도를 40-60%로 유지하는 것이 건강에 가장 이상적이라고 합니다. 옷장제습제 추천 제품을 통해 적정 습도를 유지함으로써 곰팡이와 집먼지 진드기의 번식을 막고, 알레르기 반응과 호흡기 질환의 위험을 줄일 수 있습니다. 따라서, 건강을 생각한다면 여름철 옷장제습제 추천 제품은 필수 아이템입니다.
✅습기에 탁원할 제습제 추천제품
옷장제습제 추천 전자제품 보호 및 유지



옷장제습제 추천 제품은 전자제품 보호 및 유지에도 큰 역할을 합니다. 여름철 높은 습도는 전자제품에도 악영향을 미칠 수 있습니다. 전자제품 내부에 습기가 침투하면 부식이 발생할 수 있으며, 이는 제품의 성능 저하 및 고장을 유발할 수 있습니다. 특히, 컴퓨터, TV, 카메라 등 고가의 전자제품은 습기 관리가 매우 중요합니다. 옷장제습제 추천 제품을 사용하여 실내 습도를 관리하면 이러한 전자제품을 보호하고, 수명을 연장할 수 있습니다. 고장 난 전자제품을 수리하거나 새로 구매하는 데 드는 비용을 생각하면, 옷장제습제 추천 제품을 사용하는 것이 훨씬 경제적입니다. 또한, 전자제품의 데이터 손실을 방지하기 위해서라도 옷장제습제 추천 제품은 꼭 필요합니다. 옷장제습제 추천 제품은 전자제품의 작동 환경을 최적화하여 안정적인 성능을 유지하게 해 줍니다.
생활의 편안함과 쾌적함

옷장제습제 추천 제품은 우리의 일상생활에도 큰 편안함을 제공합니다. 여름철 높은 습도로 인해 불쾌감이 증가하고, 옷이나 침구가 눅눅해지는 불편함을 겪을 수 있습니다. 옷장제습제 추천 제품을 사용하면 실내 습도가 적정하게 유지되어 이런 불편함이 크게 줄어듭니다. 건조하고 쾌적한 환경은 일상생활의 질을 높여줍니다. 특히, 요리나 샤워 후 발생하는 일시적인 습기도 옷장제습제 추천 제품을 통해 빠르게 제거할 수 있어, 곰팡이 발생을 미연에 방지할 수 있습니다. 또한, 쾌적한 실내 환경은 스트레스 해소에도 도움이 되며, 더 나은 수면 환경을 제공하여 삶의 질을 향상합니다. 결국, 옷장제습제 추천 제품은 단순한 가전제품이 아니라 우리의 생활을 더욱 편안하고 쾌적하게 만들어 주는 필수품입니다.
결론

결론적으로, 여름철 옷장제습제 추천 제품의 필요성은 건강 보호, 전자제품 보호, 그리고 생활의 쾌적함 증대라는 세 가지 측면에서 매우 중요합니다. 높은 습도로 인한 각종 문제를 예방하고, 더 나은 생활환경을 제공하기 위해 옷장제습제 추천 제품을 적극적으로 활용하는 것이 필요합니다. 옷장제습제 추천 제품은 단순히 공기를 건조하게 만드는 장비가 아니라, 우리의 건강과 일상을 지켜주는 중요한 역할을 합니다. 따라서, 다가오는 여름철에는 옷장제습제 추천 제품을 잘 활용하여 쾌적하고 건강한 여름을 보내시기 바랍니다.
'일상정보' 카테고리의 다른 글
| 자동차 등록증 재발급 온라인 신청하기 (0) | 2024.06.15 |
|---|---|
| 여의도 물빛광장 주차안내/ 찾아가는길 (0) | 2024.06.14 |
| 2024 한강 수영장 개장일 여의도 안내 (1) | 2024.06.04 |
| 우리 지역 좋은 병원 찾기 (0) | 2024.06.03 |
| 2024 숙박세일페스타 6월 숙박대전 최대 30,000원 할인 쿠폰 받아가세요 (0) | 2024.06.03 |
